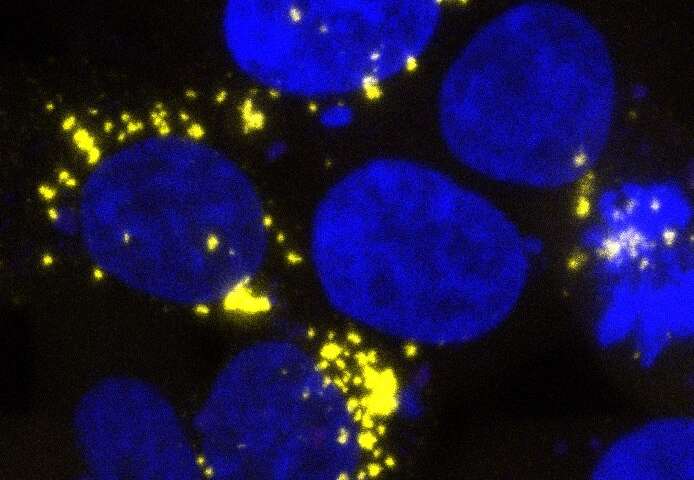

Immagine, cellule AB42 – infette da prioni beta amiloide. Credito: Prusiner lab / UCSF Institute for Neurodegenerative Diseases.
Due proteine centrali nella patologia del morbo di Alzheimer agiscono come proteine prioni-deformi che si diffondono attraverso i tessuti come un’infezione, costringendo le proteine normali ad adottare la stessa forma malriposta, secondo la nuova ricerca della UC San Francisco.
Usando nuovi test di laboratorio, i ricercatori sono stati in grado di rilevare e misurare forme di prioni auto-propaganti specifiche delle proteine beta amiloide (A-β) e tau nel tessuto cerebrale postmortem di 75 pazienti con Alzheimer. In un sorprendente risultato, i livelli più alti di questi prioni nei campioni di cervello umano erano fortemente associati a forme di esordio precoce della malattia.
La malattia di Alzheimer è attualmente definita in base alla presenza di aggregazioni di proteine tossiche nel cervello note come placche amiloidi e grovigli di tau, accompagnate da declino cognitivo e demenza. Ma i tentativi di trattare la malattia eliminando queste proteine inerti non hanno avuto successo. La nuova evidenza che i prioni attivi A-β e tau potrebbero essere alla base della malattia – pubblicata il 1 maggio 2019 in Science Translational Medicine – potrebbe portare i ricercatori ad esplorare nuove terapie che si concentrano direttamente sui prioni.
“Credo che questo studio dimostri oltre l’ombra del dubbio che beta amiloide e tau sono entrambi prioni e che il morbo di Alzheimer è un disturbo a doppio prione in cui queste due proteine canaglia distruggono insieme il cervello”, ha detto Stanley Prusiner, autore senior dello studio e Direttore dell’Istituto UCSF per le malattie neurodegenerative, parte dell’UCSF Weill Institute for Neurosciences.
“Il fatto che i livelli dei prioni appaiano anche legati alla longevità dei pazienti con Alzheimer dovrebbe cambiare il modo in cui pensiamo al futuro per lo sviluppo di trattamenti per la malattia. Abbiamo bisogno di un cambiamento epocale nella ricerca sull’Alzheimer e questo è ciò che fa questa ricerca documento, un grande cambiamento nella ricerca dell’ AD“.
Cosa sono i prioni?
I prioni sono versioni ripiegate in modo errato di una proteina che può diffondersi come un’infezione costringendo le copie normali di quella proteina ad assumere la stessa forma auto-propagante e mal ripiegata. La proteina prionica originale, PrP, è stata identificata da Prusiner negli anni ’80 come causa della malattia di Creutzfeldt Jakob (CJD) e dell’encefalopatia bovina spongiforme, nota anche come morbo della mucca pazza, che si diffuse attraverso il consumo di carne e farina d’ossa contaminata dai prioni PrP. Questa è stata la prima volta che una malattia ha dimostrato di infettare le persone non da un’infestazione di un organismo come un batterio o un virus, ma attraverso una proteina infettiva e Prusiner ha ricevuto un premio Nobel per tale scoperta nel 1997.
Prusiner e colleghi hanno a lungo sospettato che la PrP non fosse l’unica proteina capace di agire come un prione auto-propagante e che diversi tipi di prioni potrebbero essere responsabili di altre malattie neurodegenerative causate dal progressivo accumulo tossico di proteine misfoldate. Ad esempio, la malattia di Alzheimer è definita da placche A-β e grovigli di tau che gradualmente diffondono la distruzione attraverso il cervello. Negli ultimi dieci anni, studi di laboratorio presso l’UCSF e altrove hanno iniziato a dimostrare che le placche amiloidi e i grovigli tau dai cervelli malati possono infettare tessuto cerebrale sano come PrP, ma molto più lentamente.

Molti scienziati sono stati riluttanti ad accettare che A-β e tau siano prioni che si auto-propagano e si riferiscono alla loro diffusione come “prion-like” – perché a differenza dei prioni PrP, non pensavano che fossero contagiosi se non in studi di laboratorio altamente controllati. Tuttavia, rapporti recenti hanno documentato rari casi di pazienti trattati con ormone della crescita derivato dal tessuto cerebrale umano o sottoposti a trapianti della dura madre protettiva del cervello, che hanno continuato a sviluppare placche A-β nella mezza età. Prusiner sostiene che questi risultati sostengono che sia Aß che tau sono prioni anche se si propagano più lentamente dei prioni PrP altamente aggressivi.
Laboratorio di saggi biologici rivelano i proni di Aß e Tau in campioni di cervello umano postmortem
Nel nuovo studio, i ricercatori hanno combinato due test di laboratorio recentemente sviluppati per misurare rapidamente i prioni in campioni di tessuto umano: un nuovo sistema di rilevamento A-β sviluppato nel laboratorio Prusiner e un test del tau prion sviluppato in precedenza da Marc Diamondun ex membro della facoltà UCSF che ora è Direttore del Centro per l’Alzheimer e le Malattie Neurodegenerative presso l’UT Southwestern Medical Center.
A differenza dei precedenti modelli animali che potrebbero richiedere mesi per rivelare la lenta diffusione di prioni A-β e / o tau, questi saggi cellulari misurano i livelli di prioni infettivi in soli tre giorni, consentendo ai ricercatori di quantificare efficacemente per la prima volta i livelli di entrambi i prioni tau e A-β in estratti processati da campioni di cervello post-mortem. Nel nuovo studio, i ricercatori hanno applicato la tecnica al tessuto cerebrale autoptico di oltre 100 individui morti per il morbo di Alzheimer e altre forme di neurodegenerazione, raccolti da depositi negli Stati Uniti, in Europa e in Australia.
In diversi saggi comparando i campioni dei pazienti con malattia di Alzheimer con quelli morti di altre malattie, l’attività dei prioni corrispondeva esattamente alla patologia proteica distintiva che è stata stabilita in ciascuna malattia: in 75 campioni di cervello della malattia di Alzheimer, era elevata l’attività sia di A-β che di tau; in 11 campioni da pazienti con angiopatia amiloide cerebrale (CAA), sono stati osservati solo prioni A-β; e in 10 campioni di degenerazione lobare frontotemporale tau-legata (FTLD), sono stati rilevati solo i prioni tau. Un altro saggio biologico recentemente sviluppato per i prioni alfa-sinucleina ha trovato queste particelle infettive solo nei sette campioni di pazienti con atrofia multipla degenerativa del sistema legata alla sinucleina (MSA).
“Questi test sono un punto di svolta”, ha detto il co-autore e farmacista delle proteine William DeGrado, Professore di chimica farmaceutica e membro dell’UCSF Cardiovascular Research Institute, che ha contribuito alla progettazione e all’analisi dello studio corrente . “In precedenza la ricerca sul morbo di Alzheimer si è limitata ad osservare i danni collaterali da forme di proteine morte e misfold che formano placche e grovigli. Ora si scopre che è l’attività prionica correlata con la malattia, piuttosto che la quantità di placche e grovigli al momento dell’ autopsia Quindi, per sviluppare terapie e diagnostica efficaci, abbiamo bisogno di indirizzare le forme di prioni attive, piuttosto che la grande quantità di proteine nelle placche e nei grovigli “.
Vedi anche,Nella microglia la chiave per fermare la malattia di Alzheimer?.
Attività prionica A-β e Tau legate alla longevità dei malati di Alzheimer
La scoperta notevole del nuovo studio potrebbe essere la scoperta che le forme di prione auto-propaganti di tau e A-β sono più infettive nel cervello dei malati di Alzheimer che sono morti in giovane età da forme ereditarie, geneticamente guidate della malattia, ma molto meno prevalenti in pazienti che sono morti in età più avanzata.
In particolare, nel confrontato con le misurazioni globali di tau – che è noto aumentare con l’età nel cervello di Alzheimer – i ricercatori hanno riscontrato un notevole declino esponenziale dell’abbondanza relativa delle forme di prione di tau con l’età. Quando i ricercatori hanno tracciato i loro dati, hanno visto una correlazione estremamente forte tra i prioni tau e l’età dei pazienti alla morte: rispetto ai livelli globali di tau, la quantità di prioni tau nel cervello di un paziente morto a 40 anni era in media 32 volte più alto che in un paziente morto a 90 anni.
“Ricordo ancora dove ero seduto e a che ora del giorno ho visto questi dati più di un anno fa”, ha detto il coautore e conduttore dello studio, il ricercatore di neurodegenerazione William Seeley, Professore di neurologia presso la UCSF Memory and Aging Centro che dirige la neurofene neurodegenerativa UCSF Brain Bank, che ha fornito il tessuto utilizzato nello studio. “Ho visto raramente, se non mai, questo tipo di correlazione nei dati biologici umani, ora il compito è scoprire che cosa significhi la correlazione”.
La ricerca solleva una serie di domande che dovranno essere affrontate da studi futuri, incluso se le differenze nell’infettività da prioni potrebbero spiegare il mistero di vecchia data del perché il morbo di Alzheimer progredisce a tassi così diversi in pazienti diversi. Altre domande aperte risultanti dalla ricerca includono se livelli più alti di prioni nei campioni cerebrali di pazienti più giovani sono legati all’esordio precoce della malattia o quanto rapidamente progredisce e se i livelli di prione più bassi nei cervelli più anziani riflettono meno varianti “infettive” di prioni o una certa capacità del cervello di questi pazienti di smaltire proteine misfoldate.
‘L’evidenza che le forme di prione di A-β e tau svolgono un ruolo specifico nella malattia di Alzheimer -che non può essere rilevata semplicemente contando le placche amiloidi e i grovigli di tau nel cervello del paziente – solleva anche domande sugli attuali approcci alla diagnosi di Alzheimer, progettazione di studi clinici e la scoperta di nuovi farmaci’, affermano gli autori che sperano che i loro nuovi esperimenti stimolino un rinnovato interesse nello sviluppo di terapie mirate alle proteine prioniche ora misurabili.
“Abbiamo visto di recente che molte terapie per l’Alzheimer apparentemente promettenti falliscono negli studi clinici, portandoci a ipotizzare che abbiamo preso di mira le proteine sbagliate“, ha detto Carlo Condello, uno degli autori principali dello studio. “Ora che possiamo misurare efficacemente le forme di prione di A-p e tau, c’è speranza che possiamo sviluppare farmaci per impedire che si formino o si diffondano e aiutare il cervello a eliminarli prima che causino danni “.